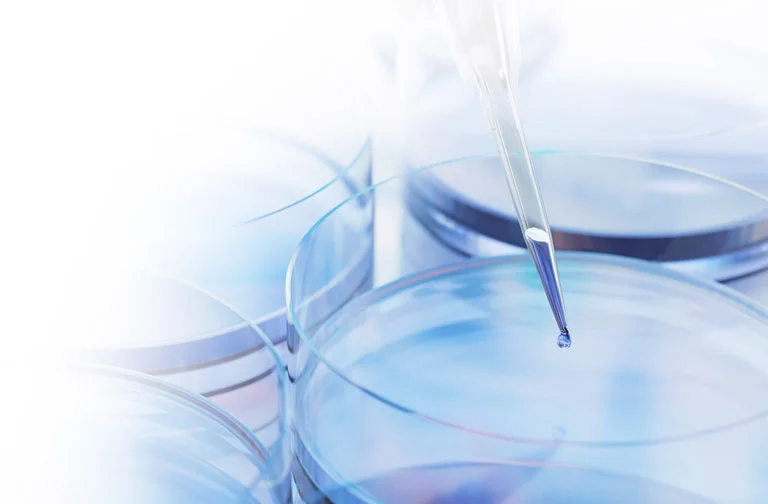

Donate to NESBR
If you or someone you love have benefitted from biomedical innovation, please consider making a tax-deductible donation to NESBR. We are a tax-exempt 501(c)(3) organization. Thank you!
Donate By credit card / PayPal
Please click on the DONATE button for credit card or PayPal donations.
Donate By check
Please make checks payable to NESBR, Inc. and mail to:
New England Society for Biomedical Research
73 Princeton Street, Suite 311
North Chelmsford, MA 01863
Be sure to include your name and address for acknowledgement purposes.
